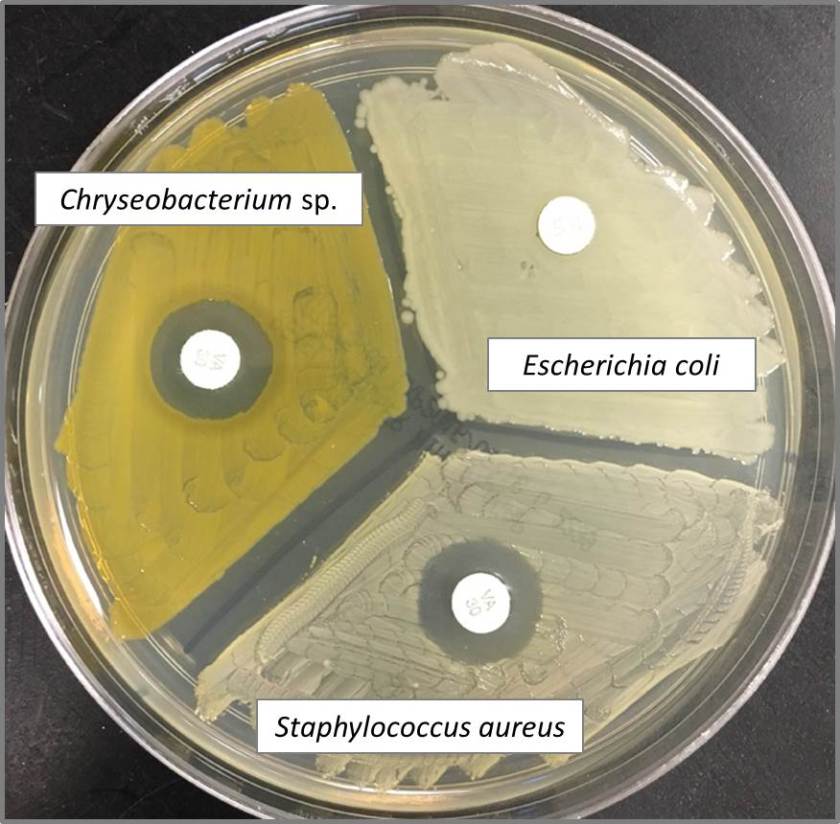
chryseo3

Case History
After failing to improve on outpatient treatment for community acquired pneumonia, a 68 year-old New England man was admitted to the hospital for refractory pneumonia. Despite the initiation of triple antibiotic therapy, he continued to spike fevers and his respiratory status progressively declined. Notably, the patient reported recent travel to Arizona.
Laboratory Identification
This sputum sample was received from an outside hospital with no accompanying clinical history. After a couple days, the sample grew wooly, white-beige colonies on both potato flake and mycobiotic agars. A cellophane tape test performed on day 6 revealed narrow septate hyphae with alternating arthrocondia and empty cells. No conidiophores were present.



While the overall morphology was most consistent with Malbranchea species, rare slightly swollen arthrocondia were identified prompting increased handling precautions and further investigation into the patient’s clinical course at the referring hospital. After several more days of growth, a repeat cellophane tape test (Figure 3) demonstrated thick-walled, barrel-shaped arthrocondia alternating with empty cells as is characteristic of Coccidioides species.
The organism was then confirmed as Coccidioides immitis/posadasii by PCR.
Discussion
Coccidioides immitis and Coccidioides posadasii are pathogenic soil fungi with limited geographic distribution. Coccidioides immitis is found primarily in California’s San Joaquin Valley, Arizona, and Mexico while Coccidioides posadasii is slightly more widespread throughout arid regions of the Americas. Although genetically distinct, the two species are clinically and morphologically identical.
Coccidioides species cause Coccidioidomycosis, also known as Valley fever, which typically presents as a primary pulmonary infection about 1-4 weeks after exposure. While the majority of infected individuals will be entirely asymptomatic, 40% of cases result in a mild, self-limiting influenza-like illness with fever, sore throat, cough, headache, pleuritic chest pain, and occasionally a maculopapular rash on the trunk and limbs. The fatigue and arthralgia associated with disease may persist for months after resolution of the pulmonary infection and is therefore sometimes referred to as “desert rheumatism”.
As with many infectious diseases, immunocompromised patients are at greater risk for developing more severe forms of the disease including extra-pulmonary manifestations. Other risk factors for disseminated disease include high inoculum exposure, chronic illness, and primary infection during pregnancy. While most infections will resolve without treatment, an extended course of azole therapy is recommended in these more complicated cases.
Since Coccidioidomycosis has relatively nonspecific symptoms, obtaining a history of exposure is often the key to the initiation of appropriate laboratory identification. Serologic testing for Coccidioides is available and is often the method of choice in the ambulatory setting. While highly specific, these tests are not very sensitive due to delayed formation and rapid clearance of the targeted antibodies. Therefore, a negative test result should not be used to exclude a Coccidioides infection especially early in the course of the disease.
In tissues and body fluids, Coccidioides is identified as round, thick-walled spherules (10-80µm) containing multiple endospores (2-5µm). When cultured at both 25°C and 37°C, Coccidioides forms wooly, white-grey colonies which may turn brown as they mature. The coarse hyphae are hyaline and septate with alternating thick-walled, barrel-shaped arthroconidia and empty cells. Although colonies usually form within three to five days, the distinctive arthroconidia may take up to 2 weeks to fully mature. Due to this delayed maturation, Coccidioides is often initially misidentified as its non-pathogenic look-a-like Malbranchea. Confirmatory testing by PCR may be performed on both bodily fluids and paraffin embedded tissue.
Coccidioides was once considered a “select agent” with the potential to pose a severe threat to human health but advancements in diagnostic techniques and antifungal medications resulted in the loss of that status in 2012. However, since inhalation of even just 10 of its highly infectious arthroconidia may result in disease, Coccidioides is still a major source of laboratory-acquired infections. Technologists should use increased biosafety precautions whenever handling specimens suspicious for Coccidioides.
-Elaine Amoresano, MD, is a 2nd year anatomic and clinical pathology resident at the University of Vermont Medical Center.

-Christi Wojewoda, MD, is the Director of Clinical Microbiology at the University of Vermont Medical Center and an Assistant Professor at the University of Vermont.